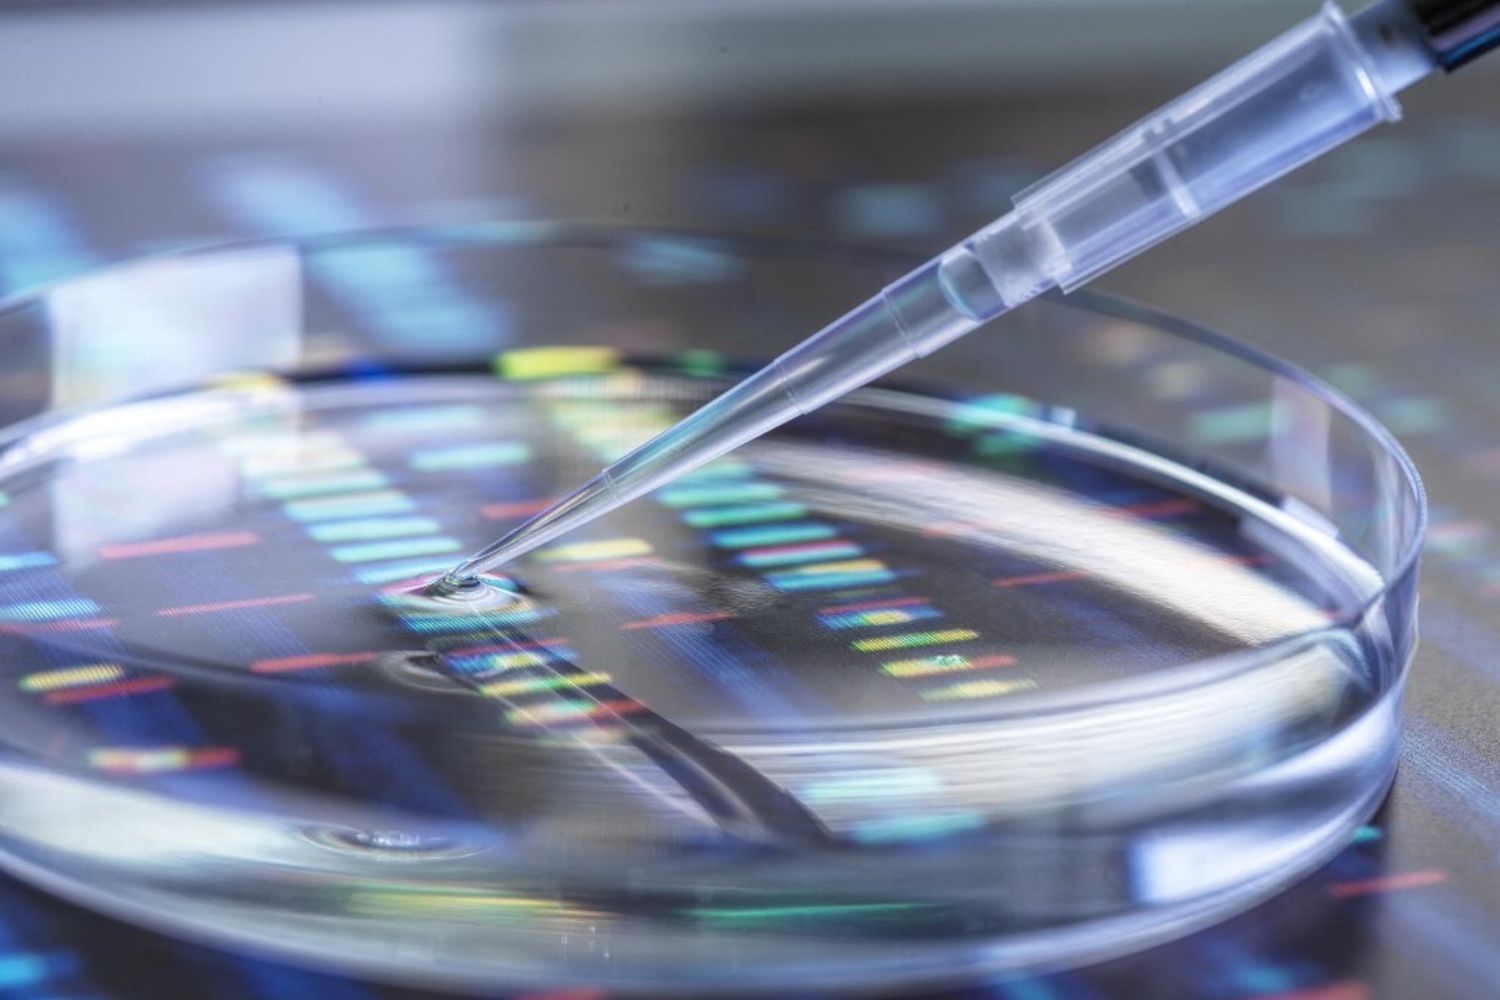
&nbsp;Studi sequenziamento del Dna

Creata la prima mappa completa del Dna del cromosoma Y

AGI - Quello che una volta era l'ultima frontiera del genoma umano, il cromosoma Y, è stato appena mappato nella sua interezza. Guidati dal National Human Genome Research Institute (NHGRI), un team di ricercatori del National Institute of Standards and Technology (NIST) e molte altre organizzazioni hanno utilizzato tecnologie di sequenziamento avanzate per leggere la sequenza completa del Dna del cromosoma Y, una regione del genoma che tipicamente guida lo sviluppo riproduttivo maschile.
I risultati dello studio, pubblicato sulla rivista Nature, dimostrano che questo progresso migliora la precisione del sequenziamento del Dna per i cromosomi, il che potrebbe aiutare a identificare alcuni disturbi genetici e potenzialmente scoprire le radici genetiche di altri.
Il sequenziamento del Dna non è semplice come leggere il materiale genetico dall'inizio alla fine di un genoma. Il Dna viene sminuzzato quando viene estratto dalle cellule, inoltre anche la migliore attrezzatura per il sequenziamento può gestire solo frammenti di Dna relativamente piccoli alla volta. Pertanto, ricercatori e medici si affidano a software speciali per mettere insieme frammenti di codice sequenziato nell'ordine corretto, come in un puzzle.
Un genoma di riferimento è un genoma separato, già messo insieme che funge da guida, simile alle immagini sulla parte anteriore delle scatole dei puzzle. E poiché il 99,9% del codice genetico della nostra specie è condiviso, qualsiasi genoma umano corrisponderebbe strettamente a un riferimento.
L'anno scorso, un team del consorzio Telomere-to-Telomere (T2T), composto da esperti provenienti da decine di organizzazioni come il NIST, ha generato il genoma di riferimento più completo all'epoca utilizzando nuove tecnologie di sequenziamento per decifrare regioni precedentemente indecifrabili del genoma.
Ma le cellule utilizzate in quel lavoro non contenevano la cosa più sconcertante di tutte, il cromosoma Y. Ora i ricercatori sono riusciti a catturare la parte più sfuggente del genoma. Il lavoro completa finalmente l'insieme dei cromosomi umani e aggiunge 30 milioni di nuove basi alla mappa del genoma umano che usiamo attualmente come riferimento, riguardanti principalmente Dna satellite difficile da sequenziare.
Queste basi rivelano 41 ulteriori geni codificanti proteine e forniscono informazioni cruciali per coloro che studiano importanti questioni relative alla riproduzione, all'evoluzione e al cambiamento della popolazione. "Ora che abbiamo questa sequenza completa al 100% del cromosoma Y, possiamo identificare ed esplorare numerose variazioni genetiche che potrebbero avere un impatto sui tratti umani e sulla malattia in un modo che non eravamo in grado di fare prima", sottolinea Dylan Taylor, genetista della Johns Hopkins University e tra gli autori principali dello studio.